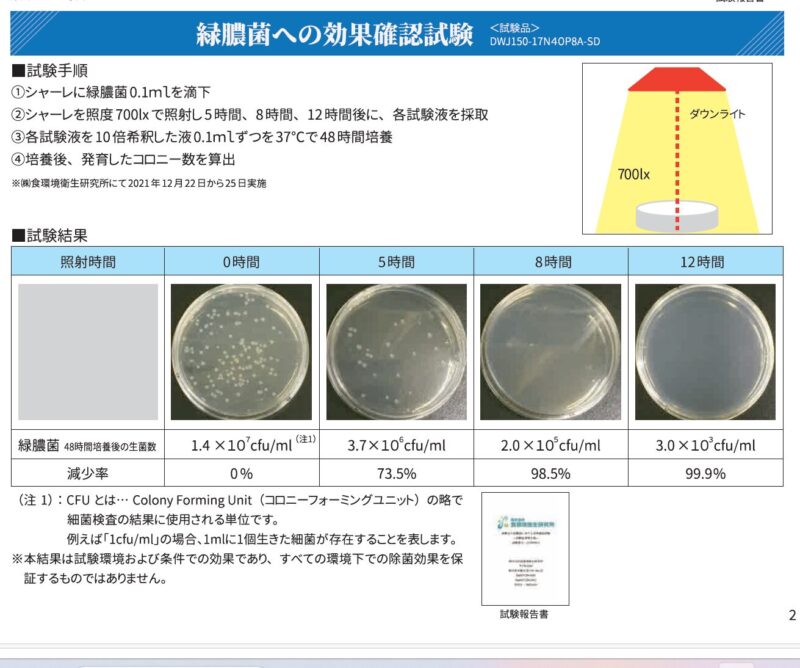

インターテクノロジーの除菌LED照明『BSL04-G230』は、最新のLED技術と強力な除菌機能を兼ね備え、業務用から家庭用まで幅広く対応します。本記事では、BSL04-G230の特長、導入効果、選び方のポイントについて解説します。あなたのニーズに最適な照明を見つけるために、ぜひ参考にしてください。

BSL04-G230とは?基本性能と特長
「BSL04-G230は、業界最先端のLED照明技術を活用し、除菌性能を搭載しています。具体的には、UV-Cライトを使用して空間内の細菌やウイルスを除去する能力を備え、安心・安全な環境を提供します。
除菌機能の仕組みと効果
BSL04-G230のUV-Cライトは、特定の波長を使って微生物を破壊する仕組みです。この技術は、病院や食品工場などの施設で高い効果を発揮しています。

導入事例:業務用から家庭用まで
BSL04-G230は、業務用から家庭用まで多くの場所で活用されています。例えば、オフィスの会議室や自宅のリビングに設置することで、空間の清潔さを維持することができます。
業務用導入事例
医療機関や食品業界での利用事例を紹介します。BSL04-G230を導入することで、消毒作業の手間を減らし、衛生管理を効率化しています。
選び方ガイド:BSL04-G230を選ぶ理由
BSL04-G230を選ぶ理由は、除菌性能だけでなく、デザイン性や省エネ性も魅力です。さらに、設置の簡便さや長寿命も大きなポイントとなっています。
競合他製品との比較
市場には多くの除菌照明が存在しますが、BSL04-G230はその中でも特にコストパフォーマンスが高く、他製品と比較しても優れた特長を持っています。


1.除菌能力
BSL04-G230は、特にUV-Cライト技術を利用した強力な除菌機能を搭載しています。UV-Cライトは、病原菌やウイルス、バクテリアを99.9%以上除去する効果があります。これに対して、競合他製品の多くはUV-AやUV-Bを使用しており、除菌効果が比較的低いことがあります。
2.消費電力と省エネ性能
BSL04-G230は、消費電力を抑えた省エネ設計が特徴です。1時間あたりの消費電力はわずか10W程度で、長時間使用しても電気代がかからないため、ランニングコストを大幅に削減できます。
3.対応する空間サイズ
BSL04-G230は、広い範囲をカバーするため、オフィスや家庭、店舗などさまざまな空間に対応します。最大で40m²まで対応できるため、広い部屋でもしっかりと除菌効果を発揮します。一方、競合製品はそれほど広い範囲に対応していないことが多く、利用できる空間に制限があります。
4.寿命とメンテナンスの手間
BSL04-G230のLEDライトは長寿命で、約20,000時間の使用が可能です。これにより、交換の頻度が少なく、メンテナンスも簡単です。多くの競合製品は寿命が短く、定期的に交換が必要であるため、維持費がかかる場合があります。
5.デザインと設置の簡便さ
BSL04-G230は、シンプルでスタイリッシュなデザインが特徴です。設置も非常に簡単で、どんな場所にもフィットします。競合製品の中には、設置が面倒だったり、デザインがインテリアに馴染まないものもあります。
6.価格とコストパフォーマンス
BSL04-G230は、除菌性能や省エネ性、デザイン性を考慮した場合、非常に高いコストパフォーマンスを誇ります。他の製品と比較して価格が少し高めではありますが、長期的に見ると、メンテナンス費用や電気代の削減で十分に元が取れると考えられます。
安全性と技術
BSL04-G230は、UV-Cライトを使用していますが、安全性にも配慮しており、内蔵のセンサーで人やペットが近づくと自動的に光を遮断する機能があります。競合製品には、安全機能が不十分なものもあるため、使用中の事故リスクが高くなることがあります。
BSL04-G230の設置とメンテナンス
設置は簡単で、あらかじめ設定された場所に設置するだけで利用可能です。また、メンテナンスが少なく、長期間にわたり安定した除菌効果を発揮します。
よくある質問(FAQ)
Q: BSL04-G230はどのような場所で使えますか?
A: オフィス、家庭、店舗など、様々な環境に対応しています。
まとめ
BSL04-G230は、除菌性能とLED照明を両立させた革新的な製品です。空間の清潔さを保つために、どんな環境でも活躍します。さらに、手軽に導入できる点も大きな利点です。今すぐ製品の詳細をチェックして、最適な導入方法をご提案します。


